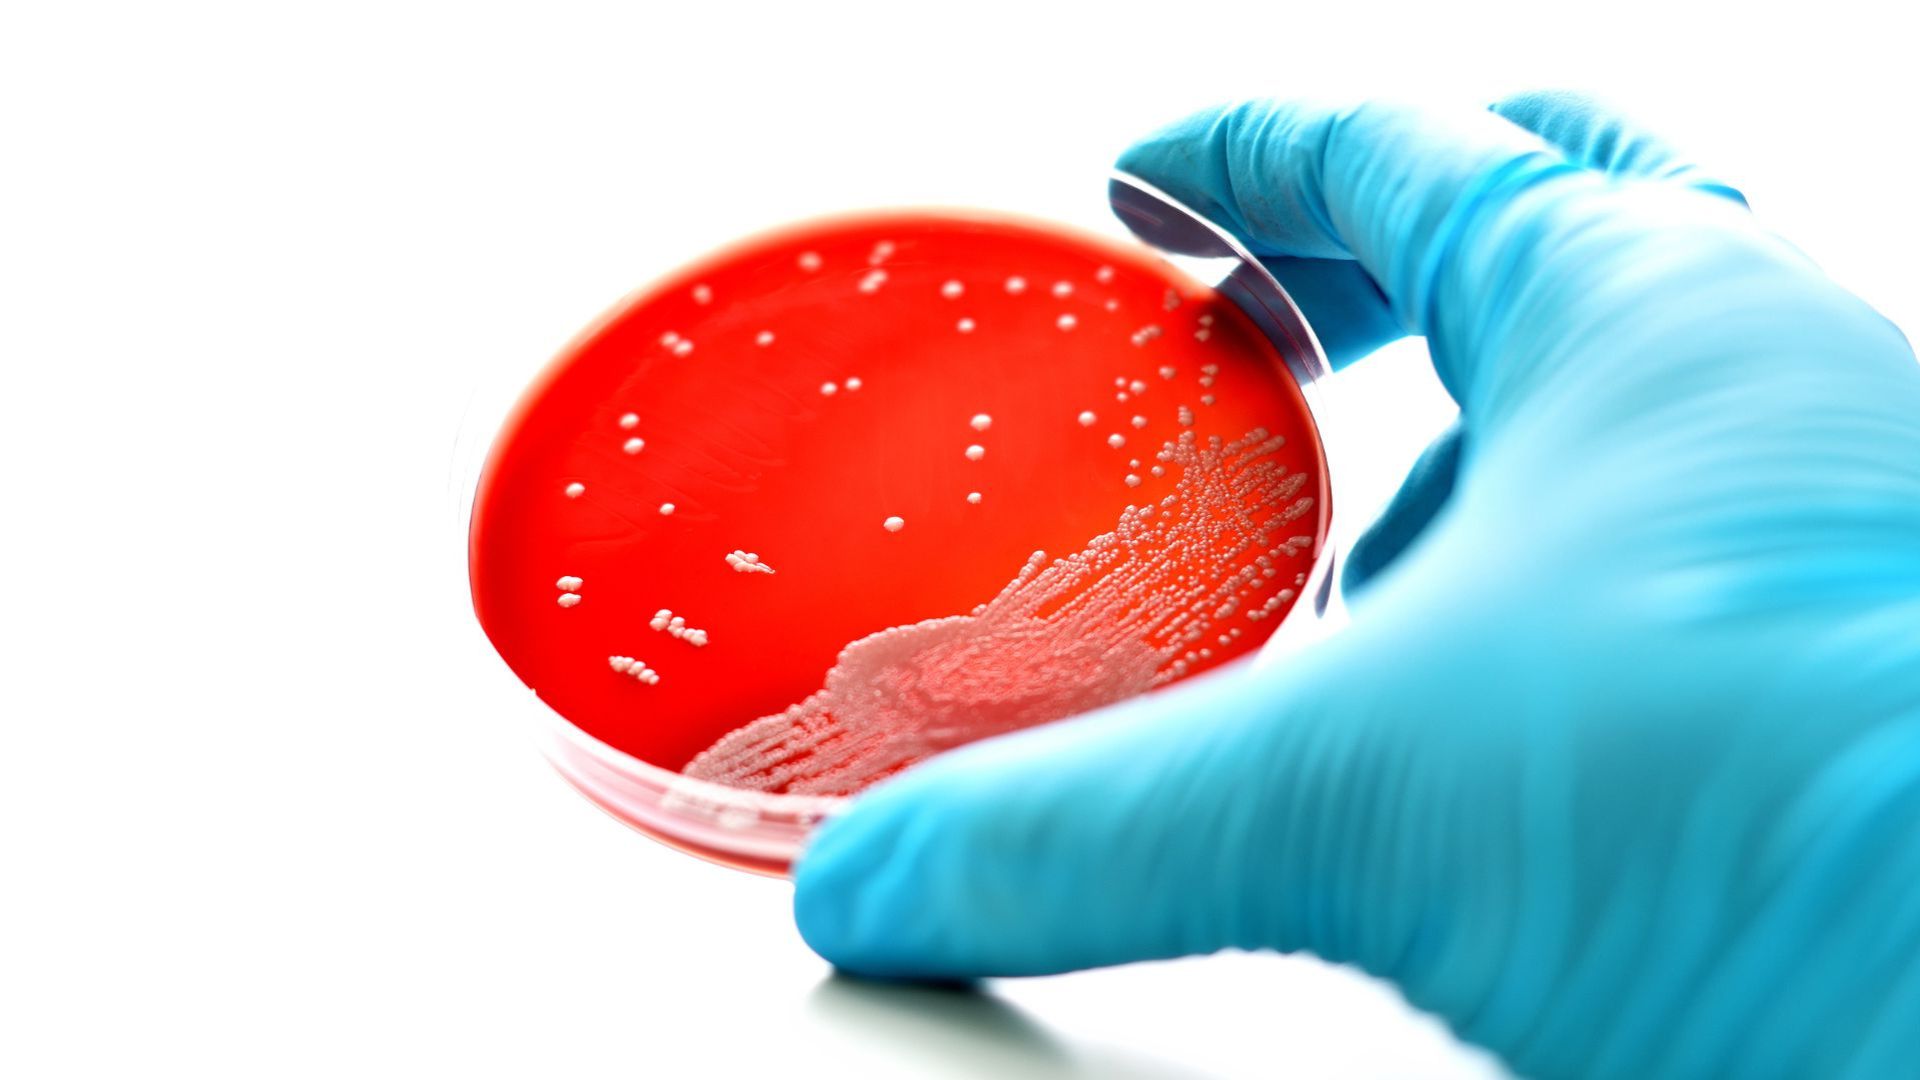
osteomielitis

Imagen
La osteomielitis es una infección del hueso grave pero tratable, y muchos mensajes que circulan sobre ella son inexactos o alarmistas.
- 1. "La osteomielitis no se cura nunca"
- 2. "Solo afecta a personas mayores"
- 3. "Si no hay fiebre, no puede ser osteomielitis"
- 4. "La osteomielitis siempre se contagia de persona a persona"
- 5. "Es solo un problema del hueso, sin riesgo para la vida"
- 6. "Con antiinflamatorios y reposo basta"
- 7. "Si la radiografía es normal, no hay osteomielitis"
- 8. "Solo aparece después de un golpe fuerte"
- 9. "Si no duele mucho, no es grave"
- 10. "No hay relación con otras enfermedades"
Imagen

- La mayoría de los casos de osteomielitis se puede curar con antibióticos adecuados y cirugía (cuando es necesaria), y el hueso se recupera en gran medida.
- El problema aparece cuando el diagnóstico se retrasa o el tratamiento se interrumpe antes de tiempo, lo que favorece que la infección pueda hacerse crónica y volver a aparecer.
Imagen

- Puede aparecer a cualquier edad, desde niños hasta personas ancianas.
- Sí es más frecuente en personas con enfermedades crónicas (diabetes, insuficiencia renal, problemas vasculares), pero no es exclusiva de ellas.
Imagen

- Aunque la fiebre es un síntoma habitual, muchas personas pueden tener osteomielitis sin fiebre evidente, especialmente mayores o con defensas bajas y en las formas de osteomielitis adquiridas por proximidad de una herida, cirugía o úlcera.
- Dolor óseo persistente, limitación de la movilidad de la zona, inflamación y enrojecimiento localizados, son signos de alerta aunque no haya temperatura alta.
Imagen

- No es una enfermedad contagiosa en el sentido habitual (como un catarro).
- La infección suele llegar al hueso desde otro foco por la sangre, o bien por contigüidad a través de una herida profunda, una úlcera crónica o después de una cirugía o fractura abierta.
Imagen

- Es una infección potencialmente grave que, si no se trata, puede extenderse, producir sepsis y comprometer la vida.
- Especialmente en casos de dolor óseo intenso, fiebre y mal estado general, sobre todo en personas con factores de riesgo, puede incluso considerarse como urgencias médicas.
Imagen

- Los antiinflamatorios pueden aliviar el dolor, pero no curan la infección.
- La osteomielitis necesita tratamiento con antibióticos durante semanas y, en algunas ocasiones, limpieza quirúrgica del foco infeccioso.
Imagen

- En fases iniciales, las radiografías pueden no mostrar cambios claros en el hueso.
- A menudo se necesitan pruebas más sensibles y específicas como resonancia magnética, tomografía computarizada y pruebas de medicina nuclear, junto a otros estudios complementarios para confirmar el diagnóstico.
Imagen

- Aunque puede seguir a una fractura ósea abierta o una cirugía del hueso, muchas osteomielitis se originan de otra manera, bien a partir de pequeñas heridas o úlceras crónicas (pie diabético), o bien a través de la sangre desde infecciones en otras partes del cuerpo.
- Incluso sin traumatismo evidente, una bacteriemia (bacterias en sangre) puede llevar la infección al hueso.
Imagen

- El dolor puede ser más o menos intenso según la persona, la localización y la fase de la enfermedad.
- En personas con neuropatía (por ejemplo, algunas personas con diabetes) el dolor puede ser discreto, a pesar de presentar una infección ósea importante.
Imagen

- La osteomielitis está claramente relacionada con enfermedades que bajan las defensas o afectan a la circulación sanguínea, como la diabetes, la enfermedad arterial periférica, la insuficiencia renal o algunos tratamientos inmunosupresores.
- Controlar bien estas patologías, revisar la presencia de lesiones en la piel o en los pies, y tratar precozmente las infecciones y heridas es clave para prevenir la infección ósea.
Si una persona presenta dolor óseo persistente, inflamación localizada o una herida que no cicatriza a pesar de unas curas adecuadas y un buen seguimiento, especialmente en el contexto de diabetes u otros problemas de salud crónicos, es importante consultar con el equipo sanitario para una valoración y diagnóstico precoces.

















